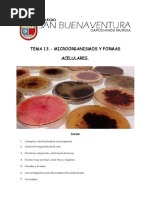

0% encontró este documento útil (0 votos)
157 vistas26 páginasIntroducción a la Microbiología
La microbiología es la ciencia que estudia los microorganismos como bacterias, hongos y virus que no son visibles a simple vista. Se originó en el siglo XIX con el descubrimiento de los microscopios que permitieron ver estos organismos. Algunos descubrimientos clave fueron la observación de "animáculos" por Anton van Leeuwenhoek en 1676 y la introducción del término "bacteria" por Christian Gottfried Ehrenberg en 1828. Los virus son estructuras acelulares que se replican dentro de las células y pueden causar en
Cargado por
Juan Alberto Espinoza AlconDerechos de autor
© © All Rights Reserved
Nos tomamos en serio los derechos de los contenidos. Si sospechas que se trata de tu contenido, reclámalo aquí.
Formatos disponibles
Descarga como DOCX, PDF, TXT o lee en línea desde Scribd
0% encontró este documento útil (0 votos)
157 vistas26 páginasIntroducción a la Microbiología
La microbiología es la ciencia que estudia los microorganismos como bacterias, hongos y virus que no son visibles a simple vista. Se originó en el siglo XIX con el descubrimiento de los microscopios que permitieron ver estos organismos. Algunos descubrimientos clave fueron la observación de "animáculos" por Anton van Leeuwenhoek en 1676 y la introducción del término "bacteria" por Christian Gottfried Ehrenberg en 1828. Los virus son estructuras acelulares que se replican dentro de las células y pueden causar en
Cargado por
Juan Alberto Espinoza AlconDerechos de autor
© © All Rights Reserved
Nos tomamos en serio los derechos de los contenidos. Si sospechas que se trata de tu contenido, reclámalo aquí.
Formatos disponibles
Descarga como DOCX, PDF, TXT o lee en línea desde Scribd